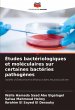
Études bactériologiques et... - Bild 1

Études bactériologiques et moléculaires sur certaines bactéries pathogènes
isolées d'Oreochromis Niloticus dans les piscicultures
Versandkostenfrei!
Versandfertig in 6-10 Tagen
26,99 €
inkl. MwSt.

PAYBACK Punkte
13 °P sammeln!
Les maladies bactériennes sont l'une des causes les plus importantes de pertes parmi les stocks de poissons. Une compréhension complète de l'agent étiologique, de la pathogenèse, de la biochimie, de l'antigénicité et de l'interrelation des facteurs liés au stress et à l'environnement est essentielle pour une gestion et un contrôle réussis. D'autre part, le tilapia du Nil (Orechromis niloticus) est considéré comme le poisson d'eau douce le plus cultivé au monde. Il contribue à l'aquaculture mondiale depuis l'époque de l'Égypte ancienne et reste une espèce majeure de poisson d'...
Les maladies bactériennes sont l'une des causes les plus importantes de pertes parmi les stocks de poissons. Une compréhension complète de l'agent étiologique, de la pathogenèse, de la biochimie, de l'antigénicité et de l'interrelation des facteurs liés au stress et à l'environnement est essentielle pour une gestion et un contrôle réussis. D'autre part, le tilapia du Nil (Orechromis niloticus) est considéré comme le poisson d'eau douce le plus cultivé au monde. Il contribue à l'aquaculture mondiale depuis l'époque de l'Égypte ancienne et reste une espèce majeure de poisson d'eau douce à élever.